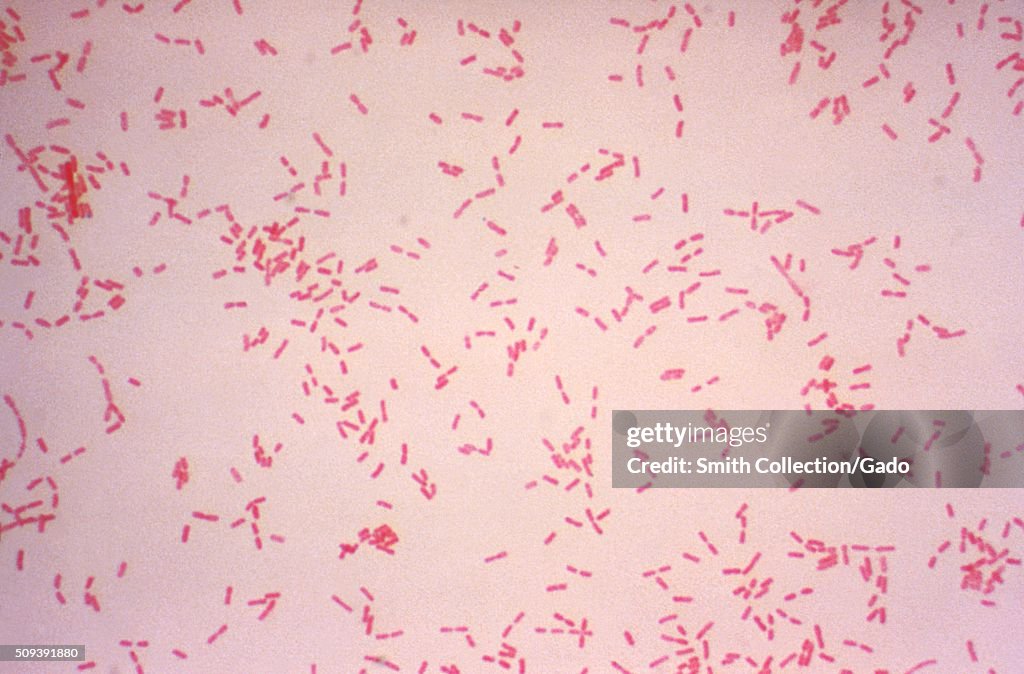
Alcaligenes faecalis. Gram stain. Image courtesy CDC/Dr. W.A. Clark

Alcaligenaceae es una familia de bacterias del orden Burkholderiales. Fue descrito en el año 1986.[1] Son bacterias gramnegativas, normalmente aerobias y en general móviles, aunque hay algunos géneros sin movilidad. Engloba bacterias tanto ambientales como patógenas. En esta familia se encuentra la bacteria altamente patógena Bordetella pertussis, causante de la tos ferina.
Taxonomía
Actualmente existen 34 géneros descritos con más de 100 especies:[2]
Referencias